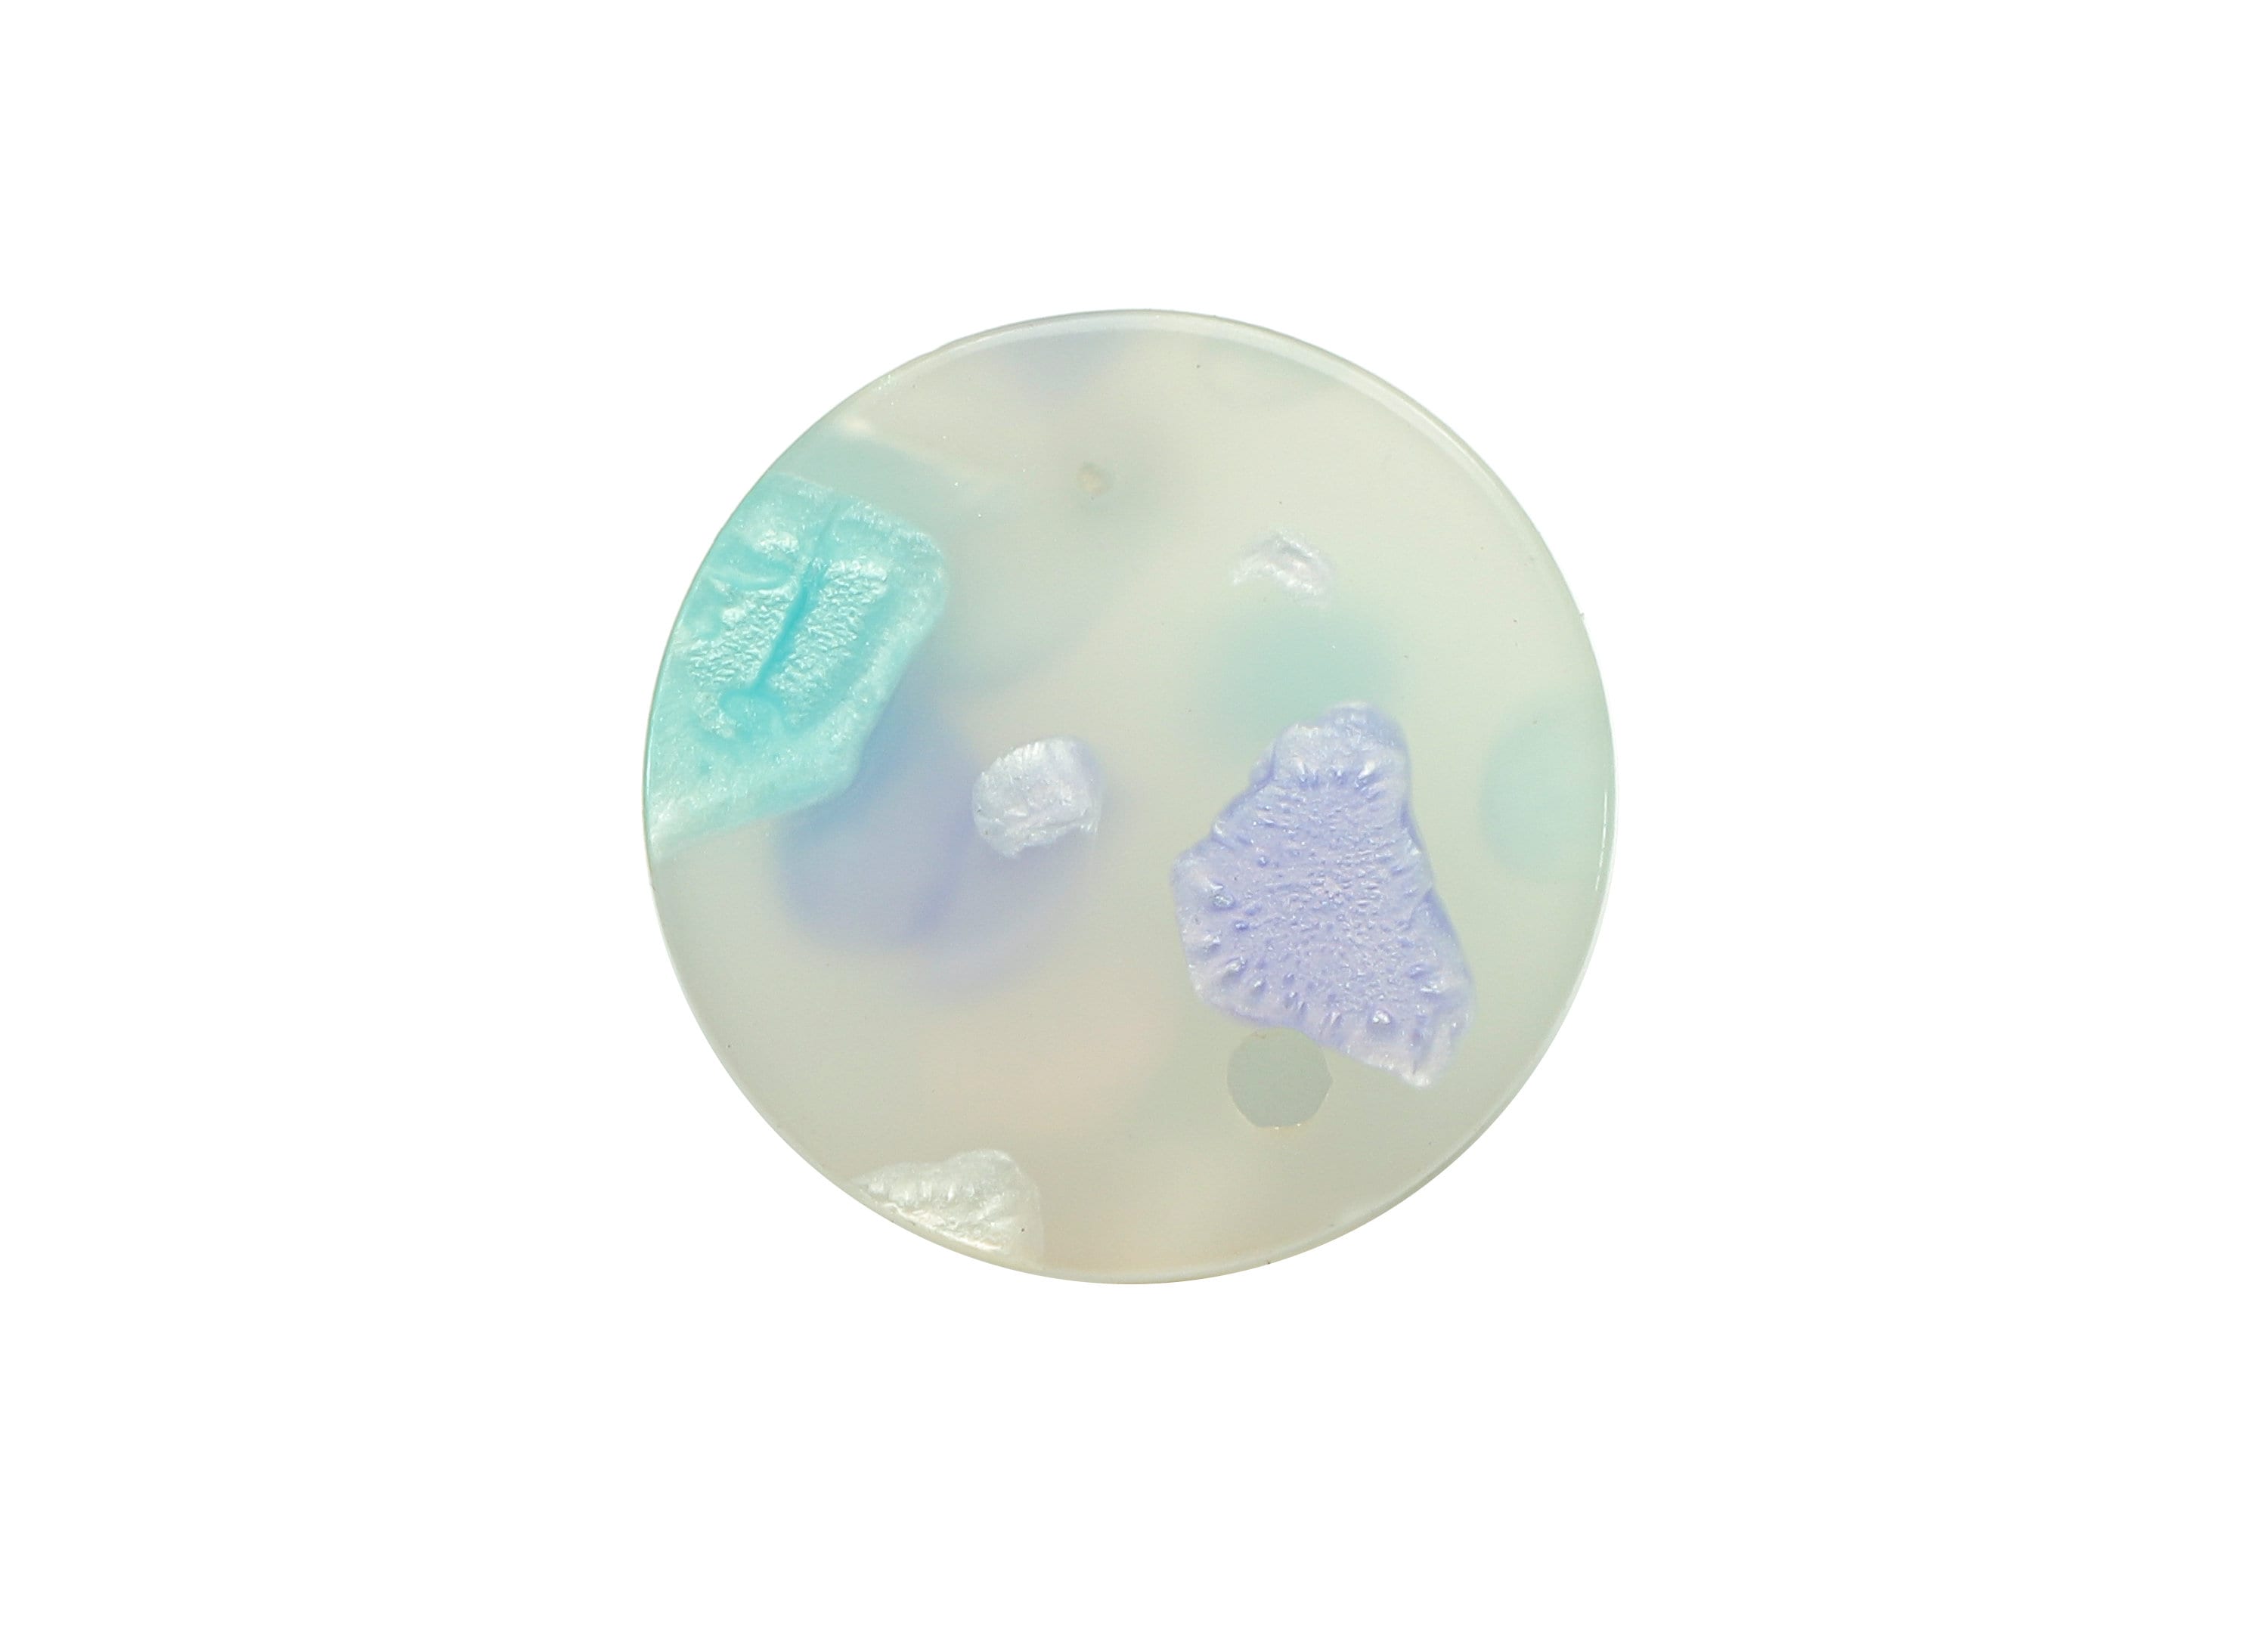
Acrylic Round Stud Earring - Circle Earrings Post With Hole - 316 Stainless Steel Stud - Color Code: A843 - 15.69x15.69x2.84mm - AC1385-A843 - DOMEDBAZAAR

Acrylic Round Stud Earring - Circle Earrings Post With Hole - 316 Stainless Steel Stud - Color Code: A843 - 15.69x15.69x2.84mm - AC1385-A843
Materials: Acrylic
Acrylic Round Stud Earring - Circle Earrings Post With Hole - 316 Stainless Steel Stud - Color Code: A843
Dimensions:
0.62\ x 0.62\ x 0.11\
(15.69mm x 15.69mm x 2.84mm)
Hole Size:
0.08\
(1.96mm)
Net Weight
0.02 oz.
0.6 gr
Colors:
Color Code: A843
Mix Color
Material:
Acrylic
316 Stainless Steel Stud
*All Products Are Lead, Nickel And Cadmium Free
*You will have a special discount for price and shipping cost about your large orders.
*We can also produce your custom and personalized models
Please contact us if you have any questions ...
Enjoy the Bazaar ...
Hypoallergenic
Reach Certified
30 Day Returns
15 OFF on All Orders
Choose options